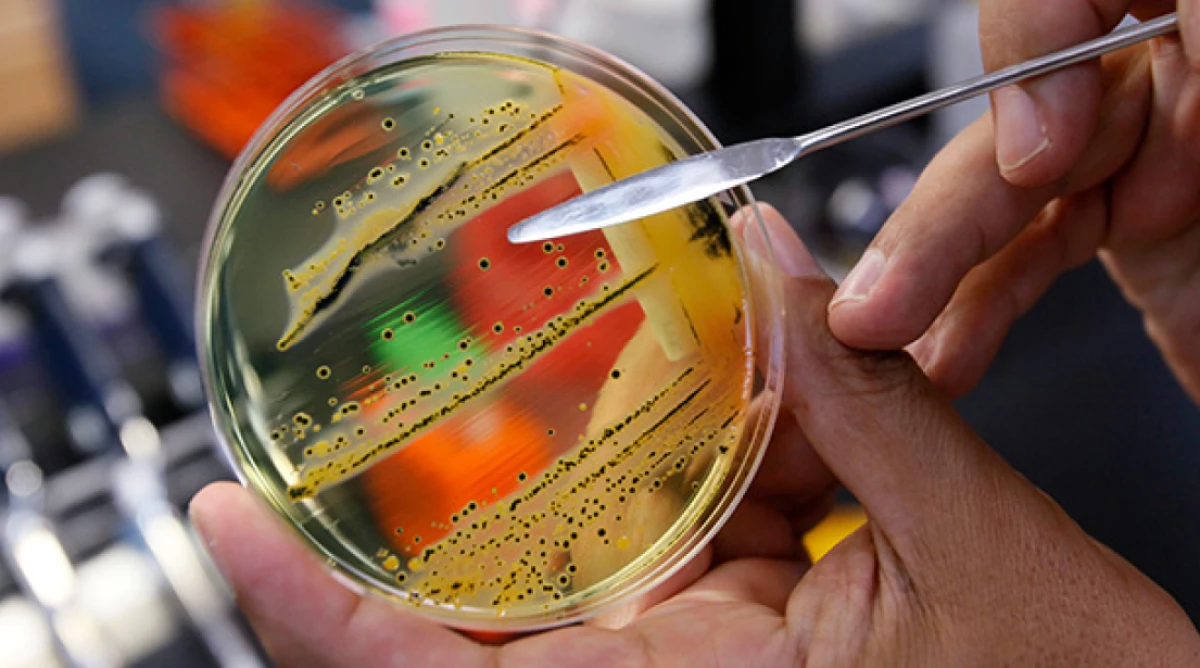

0
474
Канадські інвестори націлилися на Херсонщину
22-03-2024, 10:58
На Херсонщині перший заступник голови ОВА Дмитро Бутрій та Президент Канадсько-Української Торгової Палати Зенон Потічний підписали меморандум про співпрацю та взаєморозуміння. Про це повідомили в